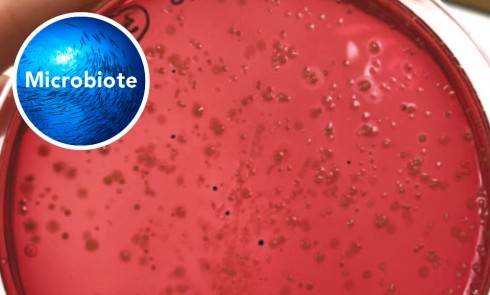

Microbiote
Diabète de type 2, nutrition et microbiote
Insulinorésistance Le diabète est caractérisé par une élévation de la glycémie à jeun. Celle-ci est initialement due, dans le diabète...Les biofilms buccaux, de véritables couffins pour les habitants du parodonte
L’objectif de cette rubrique est de rédiger la carte d’identité d’un habitant du parodonte. Elle présente l’identité de l’habitant (procaryote...Microbiote parodontal : description, moyens d’exploration et implications cliniques
Description du microbiote dans les maladies parodontales Contrairement au reste de la cavité orale, les micro-organismes qui se développent dans le sulcus...L’hôte et son microbiote parodontal : pour le meilleur et pour le pire…
Interactions de l’hôte avec son microbiote parodontal : des relations complexes L’Académie Américaine de Parodontologie définit la parodontite comme une maladie inflammatoire...Le microbiote buccal : quand les odontologistes bretons s’en mêlent
Les odontologistes rennais travaillent au sein de l’Inserm NuMeCan (nutrition, métabolisme et cancer), une unité créée en 2017 par l’association...La gestion clinique du microbiote intracanalaire dans les pathologies endodontiques
La préparation chimio-mécanique Lors de la préparation endodontique, les instruments vident et mettent en forme les canaux. Il en résulte...Physiopathologie et impact systémique du microbiote endodontique
Physiopathologie de l’infection endodontique par le microbiote buccal La nécrose pulpaire peut être un préalable à la colonisation bactérienne endodontique...Les microbiotes oraux comme nouveaux marqueurs des pathologies systémiques
Microbiotes et cavité buccale Le microbiote oral, développé dès les premières minutes de la vie d’un enfant, est composé de...